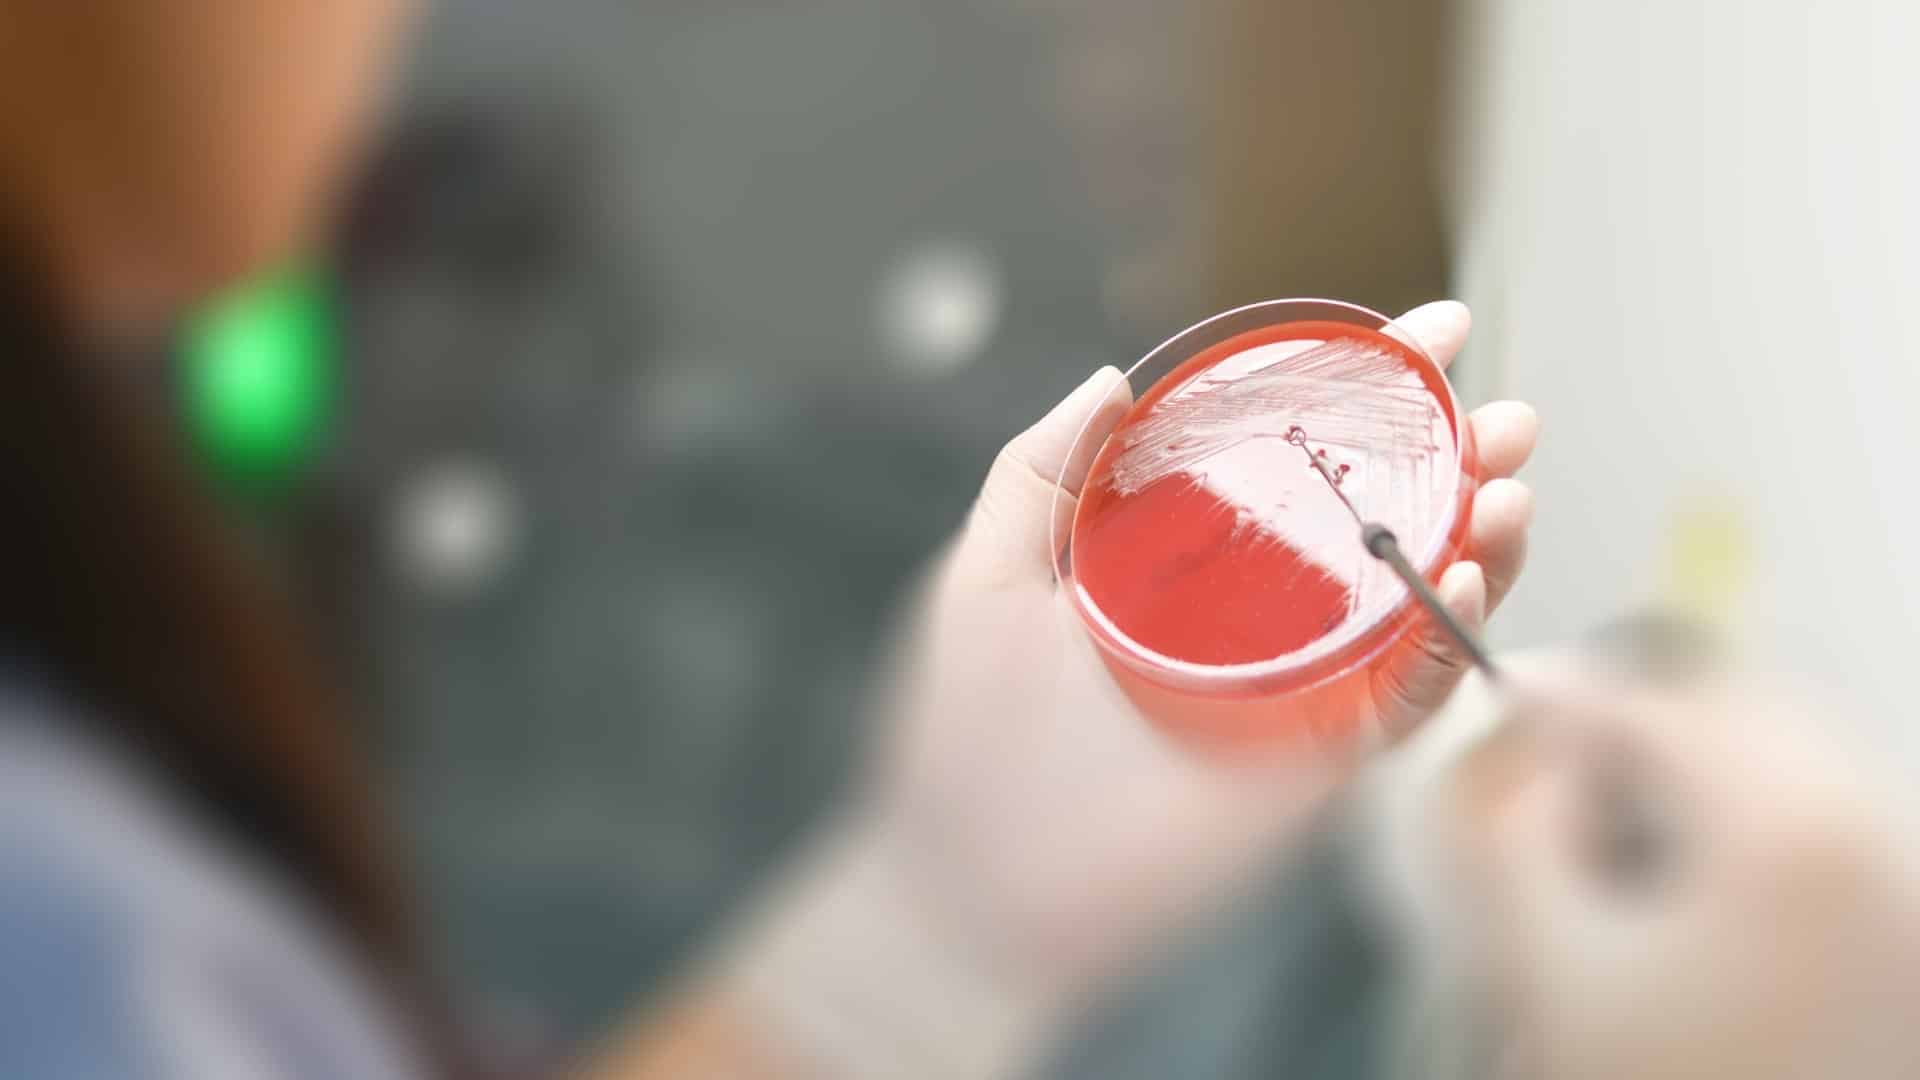

Bactérias resistentes aos antibióticos normalmente indicados para tratamentos na saúde foram encontradas em todos os pontos de coleta da represa Billings, em São Bernardo
Imagem ilustrativa
Para a coordenadora do Laboratório de Análises Clínicas Clínicas, professora e pesquisadora da Conjuscs/USCS (Universidade de São Caetano do Sul), Patrícia Montanheiro, a situação é de alerta, uma vez que pode comprometer a saúde pública da região.
O estudo realizado pela coordenadora é em complemento ao da bióloga Marta Marcondes, e chama a atenção para a resistência das bactérias Escherichia coli, Salmonela e Shigellade, que surpreendeu ao ser encontrada em todos os pontos coletados e apresentar resistência de 45% a 60% aos cerca de 15 antibióticos mais comuns testados, o que já pode ser classificada como de alto nível, por passar de 50%.
Um dos principais riscos causados pelos microorganismos – que se tornam resistentes aos medicamentos – são em casos de infectar pessoas com o sistema imunológico baixo, em que a pessoa vai adoecer e pode ser internada por cerca de 30 dias no hospital com alta gama antibióticos para o tratamento e que mesmo assim pode não dar certo.
A infecção ainda pode ocorrer pela pele ou via ingestão, e causar diversos problemas na saúde por conta da resistência no organismo.
“Não é só um risco para os humanos, mas para os animais também. Se for via oral uma disenteria bem grave, pode ser necessário ajuda hospitalar, já que remédios podem não fazer efeito. Já se for contato com a pele, uma dermatite severa pode provocar cortes os pés, causar infecções urinárias ou até complicações internas”, comenta Patrícia.
LEIA TAMBÉM: ANÁLISES ENCONTRAM RESÍDUOS FARMACOLÓGICOS EM ÁGUA DESTINADA AO CONSUMO HUMANO
Em entrevista ao RDtv, a especialista lembra que as bactérias identificadas nos organismos normalmente sofrem mutações, mesmo fora do corpo humano.
“Com o descarte incorreto de medicação em diversos locais, a exemplo das represas, há encontro da bactéria com antibióticos, e é aí que se cria a resistência. E isso não é um fenômeno anormal, mas é algo que faz com que as bactérias sobrevivam no ambiente”, explica.
O mecanismo de defesa das bactérias também é realizado com a ação humana, em diversos momentos. Exemplo disso é a não utilização correta de antibióticos ou a não realização de prescrições médicas para ingestão.
“É importante estar atento no período certo de ingestão de antibióticos. Não basta apresentar uma leve melhora, é necessário ingerir corretamente, nos dias necessários para matar a bactéria e criar resistência”, alerta.
A respeito do descarte no Meio Ambiente, Patrícia diz que o mapeamento realizado em represas tem mostrado que novas medidas devem ser tomadas para controlar a proliferação das superbactérias. Para isso, a população também deve cumprir seu papel e utilizar os medicamentos de forma adequada.
“Precisamos de cuidados para que essas bactérias não venham para a população, caso contrário, muitos vão adoecer e não terá antibiótico para eliminar esses microorganismos”, completa.
Fonte: Repórter Diário.